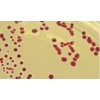

| 提交询价信息 |
| 发布紧急求购 |

价格:电议
所在地:上海
型号:BJ-0016-1327
更新时间:2018-03-08
浏览次数:964
公司地址:中国
![]()
王先生(先生)
种属类有:人、家畜类、水产类、禽类、宠物类、植物类、及花类等等(如人、大鼠、小鼠、豚鼠、猪、狗、猴、羊、牛、鸡、兔)
标本种类较多:血清血浆、全血、细胞上清液、组织匀浆、体液、尿液、肺泡灌洗液、粪便、心房水、胸腹水、脑脊髓、前列腺液、精液、阴道分泌物等等
本公司提供各种种属各种系列ELISA试剂盒, 主要用于科研方面,不用于临床诊断。可以用于检测各种指标。产品名称:艾格琼脂
英文名称:Eugonic Agar
产品规格:250g
产品用途:用于生产过程中无菌监测(Acumedia方法)
用于生产过程中无菌检测(Acumedia方法)
艾格琼脂使用方法:
1、沿铝塑袋侧边缺口处撕开或用剪刀剪开封口,取出产气包。
2、将产气包立即放入装有培养皿的2.5L厌氧培养袋中,并密封培养袋。此时产气包将会吸收培养袋内的O2 ,并同时产生CO2 。
3、一般情况下,在60分钟内,氧气被完全吸收,同时产生约20~21%的二氧化碳。
艾格琼脂注意事项
1.使用琼脂糖需要加温,请做好必要的防护措施,避免烫伤。
2.强烈建议您不要将琼脂糖粉末直接倒入沸水中,这样做会引起爆沸,溅出,致使浓度下降,还会造成结块而融化困难。正确的做法是称量一定量琼脂糖至三角瓶中,根据配制浓度加入一定量的缓冲液(与电泳缓冲液一致),加盖硅胶塞(防止温度差别造成表面结膜),微波或其他方式加热至沸腾2分钟左右,戴手套小心取出,摇匀,使之完全溶解。
3.必须保证琼脂糖完全溶解,否则造成电泳条带不清,保证完全溶解的前提下,尽量缩短加热时间。
日本根霉
粪产碱杆菌
干燥棒杆菌
白色念珠菌ATCC10231冻干粉
少根根霉
停乳链球菌
玫烟色拟青霉
营养琼脂培养基200ml
裂殖壶菌
苏云金芽胞杆菌柏氏变种 Bacillus thuringiensis var. berliner
棒曲霉
紫色直丝链霉菌
淡紫青霉
克柔念珠菌冻干粉
梨形毛霉
苏云金芽胞杆菌猝倒亚种 Bacillus thuringiensis subsp. sotto
红色红曲霉
头状秃马勃
滑菇、光帽黄伞
蜡样芽孢杆菌CMCC63301冻干粉
阿尔莱特葡萄球菌
中华根霉
灭酵母
迟缓芽孢杆菌
Anti-PTHrP/FITC 荧光素标记甲状旁腺激素相关蛋白抗体IgGMulti-class antibodies规格: 0.2ml
HSA/human Serum albumin 人血清白蛋白Multi-class antibodies规格: 10mg
胰岛素受体抗体 Anti-ISR 0.1ml
Goat anti-Mouse IgG whole serum 羊抗小鼠IgG抗血清 1ml
Fibrillarin 英文名称: 核仁纤维蛋白抗体 0.2ml
Rhesus antibody Rh phospho-PRKAA2(Ser173) 腺苷单磷酸活化蛋白激酶α2抗体 规格 0.1ml
HSA/human Serum albumin 人血清白蛋白Multi-class antibodies规格: 10mg
GP-MM ELISA Kit 大鼠糖原磷酸化酶同工酶MMMulti-class antibodies规格: 48T
Anti-VSIG4 T淋巴细胞负调节蛋白抗体Multi-class antibodies规格: 0.2ml
Rhesus antibody Rh GADD45 gamma 生长抑制DNA损伤基因45γ抗体 GADD45γ 规格 0.2ml
bFGF-4(Human basic fibroblast growth factor 4) ELISA Kit 人碱性成纤维细胞生长因子4 96T
NFIX 英文名称: 核因子1X抗体 0.2ml
Annexin VI 英文名称: 膜粘连蛋白6抗体 0.1ml
Anti-VSIG4 T淋巴细胞负调节蛋白抗体Multi-class antibodies规格: 0.2ml
Anti-Phospho-SMC1 (Ser360) /FITC 荧光素标记磷酸化染色体结构维持蛋白质1抗体IgGMulti-class antibodies规格: 0.2ml
c-erbB-2蛋白 c-erbB-2蛋白(抗原)Multi-class antibodies规格: 0.5mg
阿片样物质结合蛋白/细胞粘附分子样蛋白抗体 Anti-OPCML 1ml
SRRM2 英文名称: 丝酸/精酸相关核基质蛋白2抗体 0.1ml
phospho-EGFR (Tyr1016) 英文名称: 磷酸化表皮生长因子受体抗体 0.1ml
Rhesus antibody Rh Phospho-NMDAR2B (Tyr1336) 磷酸化谷氨酸受体2B抗体 规格 0.1ml
c-erbB-2蛋白 c-erbB-2蛋白(抗原)Multi-class antibodies规格: 0.5mg
艾格琼脂Rabbit Anti-Goat IgG/HRP 辣根过氧化物酶标记的兔抗羊IgG 0.1ml
FPR1 英文名称: 基肽受体1抗体 0.1ml
脂肪酸结合蛋白2抗体 Anti-Fabp2 0.1ml
Anti-PG-C/FITC 荧光素标记胃蛋白酶原C抗体IgGMulti-class antibodies规格: 0.2ml
Rhesus antibody Rh Phospho-TAK1(Ser412) 磷酸化转化生长因子β活化激酶1 规格 0.1ml
 免责声明:以上所展示的[BJ-0016-1327 艾格琼脂说明书]信息由会员[邦景实业ELISA试剂盒销售部]自行提供,内容的真实性、准确性和合法性由发布会员负责。
免责声明:以上所展示的[BJ-0016-1327 艾格琼脂说明书]信息由会员[邦景实业ELISA试剂盒销售部]自行提供,内容的真实性、准确性和合法性由发布会员负责。